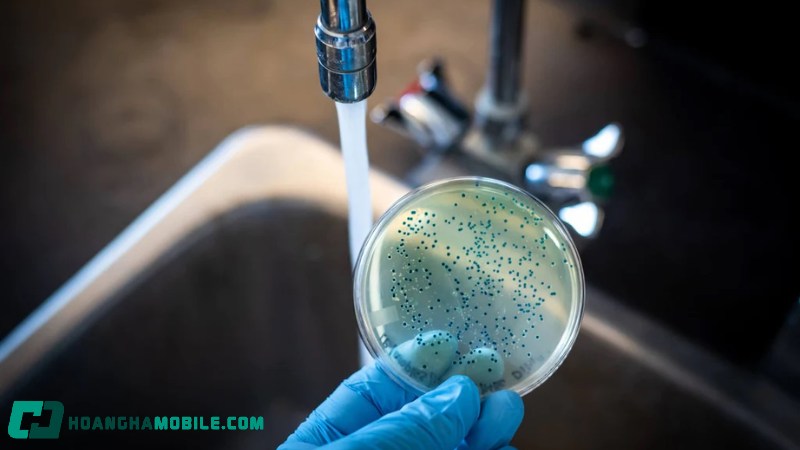

Nước RO là gì đang là thắc mắc của nhiều người hiện nay. Hiện nay nước RO ngày càng được sử dụng rộng rãi nhờ khả năng loại bỏ tạp chất và vi khuẩn hiệu quả. Bài viết này sẽ giúp bạn có cái nhìn đầy đủ từ nguyên lý lọc, ứng dụng thực tế cho đến cách đánh giá chất lượng để bạn yên tâm sử dụng nguồn nước tinh khiết mỗi ngày.
Nước RO là gì?
Nước RO còn được biết đến với tên gọi nước tinh khiết hay nước khử khoáng, được tạo ra nhờ công nghệ thẩm thấu ngược (Reverse Osmosis). Quá trình này sử dụng màng lọc RO có kích thước siêu nhỏ chỉ khoảng 0,0001 micron, đủ để loại bỏ hầu hết tạp chất, vi khuẩn, virus, kim loại nặng và các chất độc hại tồn tại trong nguồn nước.
Khi đi qua hệ thống lọc, không chỉ những yếu tố gây hại bị loại bỏ mà ngay cả các khoáng chất tự nhiên cũng bị giữ lại. Kết quả cuối cùng là nguồn nước tinh khiết gần như tuyệt đối, có độ an toàn cao và được ứng dụng rộng rãi trong sinh hoạt, y tế cũng như công nghiệp.

Nước RO có uống được không? Có tốt không?
Sau khi tìm hiểu nước RO là gì, chúng ta đã biết loại nước này hoàn toàn có thể dùng trực tiếp mà không cần đun sôi hay lọc bổ sung. Nhờ công nghệ thẩm thấu ngược, nguồn nước này loại bỏ tới 99% tạp chất, vi sinh vật và kim loại nặng, đảm bảo độ tinh khiết gần như tuyệt đối. Dù trong quá trình lọc, những khoáng chất tự nhiên như canxi hay magie cũng bị loại bỏ, song điều đó không khiến nước RO trở thành mối nguy hại cho sức khỏe.
Tuy nhiên, việc loại bỏ cả các khoáng chất có lợi khiến nhiều người băn khoăn về tác động khi sử dụng lâu dài. Nguồn nước sạch tuyệt đối nhưng thiếu khoáng có thể gây ra một số hệ lụy như làm suy giảm sức đề kháng, ảnh hưởng đến khả năng hấp thụ dưỡng chất từ thực phẩm, thậm chí liên quan đến các vấn đề sức khỏe như cao huyết áp hay viêm loét dạ dày. Vì vậy, việc dùng nước RO trong thời gian dài cần được cân nhắc và kết hợp với chế độ bổ sung khoáng hợp lý.

Tác dụng của nước RO là gì trong đời sống
Nhờ đặc tính siêu tinh khiết, nước RO được ứng dụng rộng rãi trong nhiều lĩnh vực từ sinh hoạt thường ngày cho đến y tế chuyên sâu.
Trong sinh hoạt hàng ngày
- Nước uống và nấu ăn: Nước RO loại bỏ gần như hoàn toàn tạp chất và vi khuẩn, mang lại nguồn nước an toàn cho sức khỏe. Khi dùng để nấu ăn, nước giúp thực phẩm giữ hương vị tự nhiên, không bị ảnh hưởng bởi mùi clo hay kim loại nặng.
- Làm đá viên: Đá được làm từ nước RO trong suốt, tinh khiết và không còn mùi lạ, đảm bảo vệ sinh khi sử dụng.
- Hồ cá cảnh: Giúp duy trì môi trường nước sạch, giảm thiểu nguy cơ cá mắc bệnh và kiểm soát tốt chất lượng nước.
- Máy tạo độ ẩm: Giảm tình trạng đóng cặn khoáng trong thiết bị, đồng thời cung cấp hơi nước trong lành hơn.
- Chăm sóc da: Rửa mặt bằng nước RO hạn chế kích ứng, nhờ loại bỏ các chất ô nhiễm tồn tại trong nguồn nước sinh hoạt thông thường.

Trong chạy thận nhân tạo
Ứng dụng của nước RO là gì trong chạy thận nhân tạo? Trong y tế, đặc biệt là lọc máu, nước RO giữ vai trò sống còn. Mỗi ca chạy thận cần trung bình 120 lít nước siêu tinh khiết, tương đương khoảng 22.000 lít/năm cho một bệnh nhân.
- Đảm bảo độ tinh khiết: Nước RO được loại bỏ vi khuẩn, nội độc tố, muối hòa tan và hợp chất hữu cơ, đạt tiêu chuẩn khắt khe của các tổ chức như Hiệp hội vì sự tiến bộ của thiết bị y tế (AAMI).
- Ổn định dịch thẩm tách: Nước RO giữ thành phần hóa học dịch thẩm tách ở mức chuẩn, hỗ trợ quá trình lọc máu diễn ra an toàn và hiệu quả, giảm nguy cơ biến chứng do độc tố hoặc kim loại nặng.
- Bảo vệ thiết bị: Hạn chế sự tích tụ khoáng chất trong máy, kéo dài tuổi thọ thiết bị, giảm chi phí bảo trì và duy trì hiệu suất ổn định trong điều trị.

Các ứng dụng đặc biệt của nước RO là gì?
Ngoài vai trò trong sinh hoạt và y tế, nước RO còn được ứng dụng trong nhiều lĩnh vực đặc thù, nơi yêu cầu cao về độ tinh khiết:
- Trong phòng thí nghiệm: Nước RO cung cấp nguồn nước siêu sạch, cần thiết cho các thí nghiệm hóa học, sinh học và những quy trình nghiên cứu đòi hỏi loại bỏ hoàn toàn tạp chất để đảm bảo kết quả chính xác.
- Trong sản xuất bia: Chất lượng nước quyết định trực tiếp đến hương vị và độ tinh khiết của bia. Nước RO giúp loại bỏ các yếu tố gây ảnh hưởng xấu, giữ cho quy trình ủ bia ổn định và sản phẩm đồng nhất.
- Trong ngành dược phẩm: Nước RO được sử dụng trong khâu sản xuất thuốc, pha chế dung dịch và làm dung môi để đảm bảo sản phẩm đạt chuẩn an toàn cho sức khỏe người bệnh.

Tiêu chuẩn nước RO đầu ra
Tiêu chuẩn nước RO sau khi lọc phải đáp ứng các tiêu chuẩn khắt khe để được sử dụng trong những lĩnh vực quan trọng như y tế và nước uống trực tiếp. Các quy định này do những tổ chức uy tín, điển hình là Hiệp hội vì sự tiến bộ của thiết bị y tế (AAMI) ban hành, nhằm đảm bảo an toàn tuyệt đối cho sức khỏe con người.
Tiêu chuẩn hoá sinh
Nước RO đạt chuẩn cần có nồng độ các chất hòa tan và khoáng chất ở mức cực thấp. Tổng lượng chất rắn hòa tan (TDS) thường được kiểm soát dưới 10 mg/L, trong khi các kim loại nặng như chì, thủy ngân, asen phải gần như bằng 0. Ngoài ra, các hợp chất hữu cơ, clo dư hay thuốc trừ sâu đều phải được loại bỏ để đảm bảo an toàn cho sức khỏe và đáp ứng yêu cầu sử dụng trong y tế, thực phẩm và đồ uống.

Tiêu chuẩn vi sinh
Ở khía cạnh vi sinh, nước RO tiêu chuẩn phải hoàn toàn loại bỏ vi khuẩn, virus, nấm men và các loại nội độc tố. Số lượng vi sinh vật sống sót trong nước sau lọc phải ở mức rất thấp, đạt chuẩn cho nước uống trực tiếp và dùng trong chạy thận nhân tạo. Đặc biệt, nồng độ vi khuẩn cần duy trì dưới mức quy định của các tổ chức quốc tế như AAMI hoặc WHO, đảm bảo độ tinh khiết tuyệt đối và an toàn cho người sử dụng.
Cách kiểm tra chất lượng nước RO là gì?
Bên cạnh việc hiểu khái niệm nước RO, người dùng cũng nên nắm rõ cách kiểm tra để đảm bảo nguồn nước đạt chuẩn tinh khiết và an toàn. Một số phương pháp thường được áp dụng gồm:
Dùng máy đo TDS
Thiết bị này giúp xác định lượng chất rắn hòa tan có trong nước. Cách sử dụng rất đơn giản: chỉ cần nhúng đầu dò của máy vào mẫu nước RO, kết quả sẽ hiển thị ngay trên màn hình dưới dạng đơn vị ppm. Nước RO được coi là lý tưởng khi chỉ số TDS dưới 10 ppm, và vẫn đạt yêu cầu an toàn nếu dưới 50 ppm.

Dùng máy đo độ dẫn điện
Phương pháp này đo khả năng dẫn điện của nước, phản ánh nồng độ ion hòa tan. Bạn chỉ cần đặt đầu dò của máy vào mẫu nước để thu kết quả, tính bằng µS/cm. Độ dẫn điện càng thấp, nước càng tinh khiết. Với nước RO, chỉ số thường dưới 20 µS/cm.

Máy đo pH
Cách kiểm tra chất lượng nước RO là gì? Thiết bị đo pH được sử dụng phổ biến nhất để xác định mức độ axit hay kiềm trong nước, từ đó đánh giá sự an toàn khi sử dụng.
Cách kiểm tra rất đơn giản: đặt đầu dò pH vào mẫu nước RO, kết quả sẽ hiển thị trực tiếp trên màn hình. Thông thường, nước RO tinh khiết có chỉ số pH dao động trong khoảng 5 – 7, tức là từ hơi axit nhẹ đến trung tính, hoàn toàn an toàn cho sức khỏe.

Kiểm nghiệm vi sinh vật
Để đánh giá chất lượng nước RO một cách toàn diện, việc kiểm tra vi sinh là bước quan trọng nhằm phát hiện virus, vi khuẩn hoặc các loại vi sinh vật gây hại. Nước RO chỉ được coi là đạt chuẩn khi không phát hiện sự hiện diện của vi khuẩn, đảm bảo tiêu chuẩn vệ sinh an toàn.
Có hai phương pháp kiểm tra thường được áp dụng:
- Phương pháp lọc màng: Mẫu nước được lọc qua màng đặc biệt, sau đó màng được ủ trên môi trường dinh dưỡng để theo dõi sự phát triển của vi sinh vật.
- Phương pháp nuôi cấy: Sử dụng các môi trường nuôi cấy chuyên biệt để phát hiện và định danh chính xác các loại vi khuẩn có trong mẫu nước.
Kiểm tra chất độc
Cách tiếp theo để kiểm tra chất lượng nước RO là gì? Đây là bước quan trọng để xác định sự hiện diện của các hợp chất độc hại trong nước như nitrat, clo, chloramine hay kim loại nặng (chì, asen). Kết quả phân tích phải đáp ứng các giới hạn an toàn do những tổ chức uy tín như EPA hoặc AAMI quy định, tùy thuộc vào mục đích sử dụng nước (uống trực tiếp hay phục vụ y tế).
Hai phương pháp thường được áp dụng là:
- Dùng bộ đo màu: Cho thuốc thử vào mẫu nước, nếu có chất độc, dung dịch sẽ đổi màu. Mức độ màu sắc giúp xác định nồng độ chất cần kiểm tra.
- Phân tích trong phòng thí nghiệm: Mẫu nước được gửi tới các đơn vị chuyên môn để tiến hành phân tích chi tiết, từ đó cho kết quả chính xác hơn về các thành phần độc hại.

Bộ kiểm tra độ cứng
Dụng cụ này được dùng để xác định hàm lượng ion canxi và magie trong nước là hai thành phần chính gây nên độ cứng. Cách kiểm tra khá đơn giản: nhỏ thuốc thử vào mẫu nước và theo dõi sự đổi màu để xác định mức độ. Với nước RO đạt chuẩn, chỉ số độ cứng thường ở mức rất thấp, dưới 60 mg/L (tương đương khoảng 3,5 grains per gallon), đảm bảo an toàn khi sử dụng cho cả sinh hoạt và thiết bị gia dụng.

Kiểm tra bằng mắt thường
Cách đơn giản nhất để kiểm tra chất lượng nước RO là gì? Đây là cách đơn giản nhất để đánh giá sơ bộ chất lượng nước. Chỉ cần rót nước RO vào một vật chứa trong suốt rồi quan sát dưới ánh sáng. Nước đạt chuẩn phải có màu trong vắt, không xuất hiện cặn lắng hay vẩn đục. Nếu phát hiện dấu hiệu bất thường, đó có thể là biểu hiện nguồn nước chưa đạt độ tinh khiết cần thiết để sử dụng an toàn.

Khi nào nên lắp đặt hệ thống lọc nước RO?
Việc đầu tư hệ thống lọc nước RO mang lại nhiều lợi ích thiết thực, không chỉ cho gia đình mà còn cả cho nhu cầu thương mại:
- Bảo vệ sức khỏe: Công nghệ thẩm thấu ngược loại bỏ tới 99% muối hòa tan, vi khuẩn, ký sinh trùng, chất hữu cơ và các tác nhân gây hại khác. Nhờ đó, nguồn nước đầu ra an toàn hơn cho việc uống trực tiếp và chế biến thực phẩm.
- Tiết kiệm chi phí lâu dài: Thay vì phụ thuộc vào nước đóng chai, hệ thống RO cung cấp nguồn nước tinh khiết ổn định với chi phí sử dụng thấp, giúp giảm đáng kể chi tiêu hàng tháng.
- Đa dạng mục đích sử dụng: Hệ thống RO phù hợp cho nhiều nhu cầu khác nhau, từ sinh hoạt tại gia đình cho đến nhà hàng, văn phòng hay cơ sở kinh doanh, đảm bảo nguồn nước sạch cho uống, nấu ăn và các hoạt động khác.
Những lưu ý quan trọng khi lựa chọn sử dụng nước RO là gì?
- Chất lượng nguồn nước: Tìm hiểu đặc điểm nguồn nước đầu vào để biết rõ nguy cơ ô nhiễm.
- Kiểm tra nước: Thực hiện kiểm tra để xác định tạp chất như kim loại nặng, clo, nitrat, florua hoặc vi khuẩn.
- Dung lượng hệ thống: Ước tính nhu cầu tiêu thụ hàng ngày của hộ gia đình hoặc cơ sở y tế.
- Kích thước bể chứa: Chọn bể đủ lớn để cung cấp nước ổn định cho sinh hoạt hoặc điều trị.
- Lọc thô (trầm tích, than hoạt tính): Loại bỏ hạt lớn, clo và chất độc có thể làm hỏng màng RO.
- Màng RO: Thành phần quan trọng nhất, loại bỏ phần lớn chất rắn hòa tan và độc tố.
- Lọc sau: Thường là than hoạt tính, giúp cải thiện mùi vị nước.
- Thay lõi lọc: Kiểm tra chu kỳ thay lõi lọc, chi phí thay thế và bảo trì.
- Dễ bảo trì: Ưu tiên hệ thống dễ tháo lắp, có hướng dẫn rõ ràng.
- Chứng nhận chất lượng: Chọn hệ thống đạt chuẩn NSF/ANSI hoặc AAMI để đảm bảo an toàn.
- Chi phí đầu tư: Tính cả chi phí ban đầu và chi phí dài hạn cho thay lõi, bảo dưỡng, sửa chữa.
- Áp lực nước: Đảm bảo áp suất nước đầu vào đủ để hệ thống hoạt động hiệu quả.
- Bơm tăng áp: Nếu nguồn nước yếu, nên lắp thêm bơm tăng áp để nâng cao hiệu suất.
- Tỷ lệ thu hồi: Kiểm tra lượng nước tinh khiết so với nước thải, ưu tiên hệ thống có tỷ lệ cao.

Lời kết
Qua những thông tin trên, chúng ta đã tìm hiểu rõ nước RO là gì? Có thể thấy nước RO không chỉ mang lại nguồn nước tinh khiết mà còn đóng vai trò quan trọng trong sinh hoạt, y tế và công nghiệp. Việc nắm rõ tác dụng cũng như tiêu chuẩn chất lượng của nước RO sẽ giúp bạn lựa chọn và sử dụng hiệu quả hơn, đồng thời bảo vệ sức khỏe lâu dài.
- TOP 11 cây lọc nước nóng lạnh chính hãng, chất lượng tốt nhất hiện nay
- Máy lọc nước Coway có tốt không? Gợi ý 5 mẫu bán chạy nhất
*Sưu tầm:internet